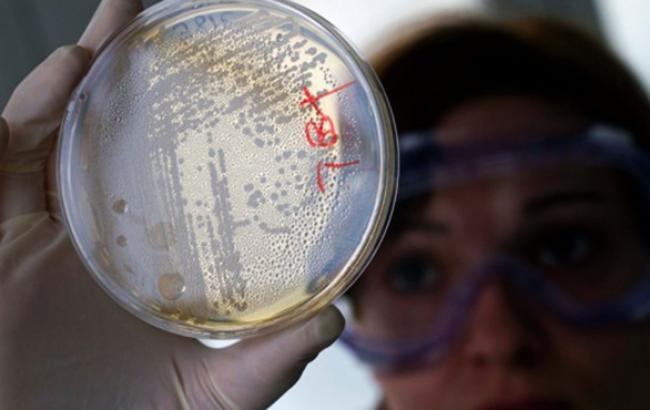

Глава ДЕС Києва прогнозує відновлення використання води в Бортничах до 2 лютого
Джерело фото:telegraf.com.ua
Джерело фото:telegraf.com.ua
Начальник Головного управління Держсанепідслужби в Києві, головний санітарний лікар Києва Олег Рубан прогнозує відновлення використання води в Бортничах до 2 лютого. Про це він заявив на брифінгу, передає кореспондент РБК-Україна.
"Коли ми отримаємо негативні результати за всіма показниками, ми дамо згоду на використання води в мережі споживання. Я сподіваюся, що на цьому тижні всі почнемо", - заявив Рубан.
Також він зазначив, що по більшості показниках вода вже придатна для вживання.
"За останній тиждень у нас не був зареєстрований жоден факт відхилення за бактеріологічними показниками. А невідповідність у нас ще є за органолептичними та хімічними показниками з перевищенням каламутності, аміаку і кольоровості", - заявив Рубан.
Нагадаємо, за даними ДЕС, забруднення водопровідної води в Бортничах сталось через несвоєчасне виявлення проривів в каналізації.

